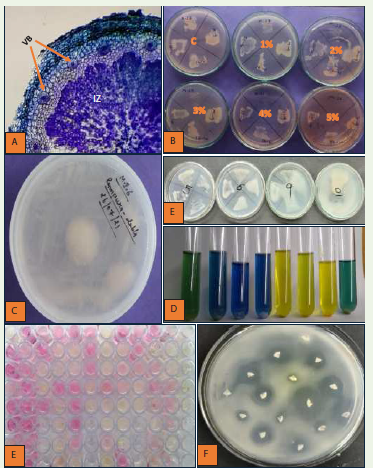

Research Article
Phenotypical, Biochemical and Plant Growth Promoting Activities of Microsymbionts Associated with Melilotus indicus in Central Aravalli Region
Amit Yadav, Sonam Choudhary, Ghanshyam Sharma and Indu Singh Sankhla*
Department of Botany, University of Rajasthan, Jaipur, India
*Corresponding author: Indu Singh Sankhla, Department of Botany, University of Rajasthan, Jaipur India. E-mail Id:induiitkgp@gmail.com
Copyright: © Yadav A, et al. 2025. This is an open access article distributed under the Creative Commons Attribution License, which permits unrestricted use, distribution, and reproduction in any medium, provided the original work is properly cited.
Article Information: Submission: 06/06/2025; Accepted: 11/07/2025; Published: 16/07/2025
Abstract
The present investigation deals with the phenotypic, biochemical and plant growth promoting activities of root nodule bacteria of Melilotus indicus. A total of 51 isolates were isolated from different sites in the Central Aravalli region. In this study, we found that bacterial colonies showed variation in their colonial
characteristics, but most of the colonies were white, opaque, mucilaginous and raised. In salinity tolerance, most of the isolates showed high tolerance and grew up to 4-5% salt concentration, but growth was reduced. In the pH tolerance test, all isolates showed growth from pH 5 to 10. In our investigation, we found that root nodule bacterial strains of Melilotus indicus plants have diverse biochemical and plant growth promoting activities. Sugar utilization and antibiotic resistance varied among isolates; fructose was the most utilized sugar, while adonitol was the least. Most isolates were resistant to nitrofurantoin and carbenicillin. Catalase and oxidase activities were present in most isolates. Many isolates produced IAA (42), ammonia (43), and solubilized phosphate (14). Pectinase, cellulase and amylase activity were also noted in a few isolates. The findings highlight the functional diversity of Melilotus indicus root nodule bacteria and their potential applications in sustainable agriculture. Overall results indicated that Melilotus indicus is associated with a wide range of rhizobia. Such type of root nodule bacterial strains can be utilized as a part of biofertilizers to enhance legume crop productivity, sustainable agriculture and reduce the use of chemical fertilizers.
Keywords:Aravalli; Root Nodule Bacteria; Plant Growth Promoting Activity; Melilotus Indicus
Introduction
Nitrogen is a critical essential element for all living organisms.
It aids in plant growth, development and crop yield. However, its
availability in the environment is approximately 78%, but not in
a plant accessible form. In this era, with an increasing population,
nutrient paucity in soil leads to a global food production chain crisis.
To feed the people, it is vital to amplify the food production and yield
of crops. For this, farmers use chemical nitrogen fertilizers which
not only extortionate but also lead to an imbalance in microbial
diversity, decrease soil fertility and cause environmental pollution,
such as polluting water resources[1-3]. Globally, Nitrogen fertilizer
consumption was 112.5 million tons in 2015 and is currently
approximately 120 million tons, which is likely to increase with the
world population[4,5]. So, it is crucial to and an alternative approach
which not only ecofriendly but also economical and enhances the
yield. Biological nitrogen fixation is the prime naturally governing
alternative in which microsymbionts convert free nitrogen to plant accessible
form either symbiotically or free-living. The primary source
of nitrogen in the ecosystem is the symbiotic relationship. Legumes
and microsymbionts, symbiotic relationships makeup over 60% of
total BNF [6]. Fabaceae, more oen known as legumes, is the third
largest family aer Asteraceae and Orchidaceae and it consists of
around 770 genera and 19500 species[7,8]. Rhizobia have the ability
to form root and stem nodules and establish symbiotic relationships
with leguminous plants [9].Currently, rhizobia with 21 genera are
classified into three classes: alpha proteobacteria, beta proteobacteria
and gamma proteobacteria [10].
Melilotus is a forage legume of Fabaceae; it comprises
approximately 25 species of annual or perennial herbs distributed
throughout the world, native to Africa, Europe and Asia [11,12].
In India, three species (Melilotus albus, Melilotus offcinalis and
Melilotus indicus) have been reported, while two Melilotus indicus
and Melilotus albus have been reported in Rajasthan [13]. Melilotus
indicus (Indian sweet clover) is a Eurasian species, is now found
globally. It naturally grows in the Aravalli range, the oldest folded
mountain system, known for its rich legume biodiversity. Although
much research has focused on cultivated crops, the microsymbionts
of wild legumes in the Aravalli region remain understudied [14].
Recently, wild legume microsymbionts have drawn interest
due to their capability to bear stressful conditions like drought,
salinity and temperature. So, there is a scope to characterize their
microsymbionts and inoculate them in cultivated plants to increase
productivity and soil fertility. Due to little attention to the diversity
of its microsymbionts, Melilotus indicus from the Aravalli region was
selected for its potential as a host plant to explore and utilize native
root nodule bacteria in sustainable agriculture.
Materials and methods
Survey, Collection and Morphological and Anatomical study of root nodules:
A survey was conducted during the winter season (December-
March) to check the nodulation status of Melilotus indicus. Nodules
were collected from different sites of Jaipur and Ajmer during
February - March. The plants were excavated with a root system
during collection, and nodules were excised. Subsequently, the
morphological characteristics of collected nodules were recorded and
anatomical studies were done through transverse and longitudinal
sections of fresh root nodules.Isolation and purification of root nodule bacteria:
For isolation, the excavated root nodules were washed with tap
water and sterilized according to standard methods [15]. Sterilized
nodules were squeezed by sterile forceps and then streaked on Congo
Red Yeast Extract Mannitol Agar plates (a selective media for root
nodule bacteria) and incubated at 28°C for 48-72 hours. To attain
the pure culture, single colonies were picked up and re-streaked.
Once suffcient growth was observed, these plates were stored at
4°C for further study of phenotypic, biochemical and plant growth
promoting activities of purified isolates.Colony characteristics:
Colony characteristics of root nodule bacterial strains, such as
colony colour, mucilage production, gumminess, elevation, shape,
margin, texture, opacity, and surface appearance, were recorded for
each isolate. For this, all isolates were streaked on YEMA plates and
incubated at 28°C for 48-72 hours and observed regularly to monitor
the development and distinct features of the bacterial colonies.Phenotypic characterization:
All isolated root nodule bacterial strains were characterized
for their phenotypic attributes such as acid or alkali production,
NaCl tolerance, pH tolerance, sugar utilization ability and intrinsic
antibiotic resistance pattern.NaCl tolerance:
For determination of NaCl tolerance, all the bacterial isolates
were streaked on the YEMA plates supplemented with dierent
NaCl concentrations (0.5%, 1%, 2%, 3%, 4% and 5%) to assess their
tolerance to salinity. Aer inoculation, plates were incubated at 28°C
for 3-4 days and the growth of isolates at dierent concentrations was
noted [16].pH tolerance:
To assess tolerance to acidic or alkaline pH, bacterial cultures were
streaked on to YEMA plates with a pH range of 5 to 10 and incubated
for 48–72 hours at 28°C. The pH of the medium was adjusted using
1N NaOH and 1N HCl to achieve the target pH range. [16]. The
visible growth at different pH values was recorded as positive results.Acid or alkali production:
This test was performed to check whether bacterial isolates show
an acidic or alkaline reaction. For this, YEM broth supplemented
with bromothymol blue was used. Inoculated tubes were incubated at
28°C and 100 rpm for 3-4 days in a shaking incubator. Initially, broth
colour was green at neutral pH; acid producing isolates changed it to
yellow, while alkali producing isolates changed it too blue [15].Sugar utilization pattern:
All bacterial strains were tested for their sugar utilization pattern
with 21 different sugar discs. For this, 24 well plates containing
Andrade’s peptone water were inoculated with freshly grown root
nodule bacterial cultures. One sugar disc was placed in each well.
The plates were incubated at 28°C for 48 hours. A positive sugar
utilization result was indicated by the development of a pink colour
in the medium.Intrinsic antibiotic resistance:
The antibiotic susceptibility or resistance of root nodule bacterial
strains was assessed using the antibiotic disc method [16]. For this,
YEMA plates were used as medium. Fresh cultures of root nodule
bacterial strains were evenly spread (swabbed) on the media and
antibiotic discs were placed on the plates. Further, these plates were
incubated at 28°C for 24-48 hours. The presence of clear zone (zone of
inhibition) around each disc was recorded as susceptibility of isolates
for the respective antibiotics.Biochemical and PGP activities of isolates:
All the isolates were characterized for their various biochemical
and PGP activities including oxidase activity, amylase production,
indole production, nitrate reductase, citrate utilization, gelatin
hydrolysis, catalase activity, protease activity [16], cellulase activity
[17], phosphate solubilization [18], Indole Acetic Acid production
[19] and ammonia production [20].Results and Discussion
The nodulation status of Melilotus indicus at seven sampling sites
including the Rajasthan University Campus, and Niwaru (Jaipur),
as well as Doomara, Govindgarh, Rampura Dabla, Akhepura and
Pisangan (Ajmer), was successfully studied. [Figure 1A-1B] illustrates
the overview and survey of various sampling sites. During the survey,
Figure 1:Sampling sites and root nodule collection in Aravalli region (A &B),
Field view of Melilotus indicus plant (C&D) and Developmental stages and
Morphology of root nodules (E)
Melilotus indicus was consistently observed at all sampling sites
[Figure 1C-1D] with nodulation present at each location across both
Jaipur and Ajmer, indicating its widespread presence and symbiotic
activity in these regions. Aer careful examination of the excavated
root system, it was observed that nodules were mainly present on
secondary and tertiary roots rather than primary and crown regions.
Morphology of the root nodules showed variation during their
developmental stages as shown in [Figure 1E]. In the initial stage, root
nodules were globular to oblong, but as they matured, they became
elongated and branched. The colour of nodules was dark brown
to black when they matured but initially, they were light brown.
Similar to the present study, the morphology of root nodules of 3
genera (Trifolium, Melilotus and Medicago) of the tribe Trifoliae was
investigated by other researchers and it was found that in these genera
initially the nodules were spherical, but matured ones were cylindrical
or variously lobed [21]. A similar study was also conducted on 5 wild
legumes (Alhagi murarum, Melilotus indicus, Medicago intertexta,
Trifolium resupinatum and Trigonella hamosa) of the Nile Valley
and it was observed that the nodules of Melilotus indicus, Medicago
intertexta were elongated and sometimes branched, while nodules
of Alhagi murarum, Trifolium resupinatum and Trigonella hamosa
were globose to elongated [22]. For anatomical studies, we took
transverse and longitudinal sections of root nodules and subsequently
stained them with toluidine blue and then observed them under the
microscope. The sections of root nodules clearly showed the presence
of vascular supply and an infection zone (bacteroid) within the cortex
region as shown in [Figure 2A]. Similar findings were reported by
other researchers, who observed bacteroid-filled infection zones in
nodules collected from the Thar Desert [23,24].
A total of 51 root nodule bacterial strains were isolated and
purified from root nodules of Melilotus indicus. All isolates showed
immense growth on CR-YEMA media. Colony characteristics of
isolates showed variations [Table 1], but most of the colonies were
white, opaque, mucilaginous, with smooth margins and raised
[Figure 2B]. Similar to our results, variations in colony characteristics
of the root nodule bacterial strains were also reported by other
researchers[23,24]. In the NaCl tolerance test, 30 isolates showed
growth up to 4%, while 11 isolates grew up to 5% concentration,
which means they show high tolerance towards salinity. Results for
NaCl tolerance are shown in [Table 2] and [Figure 2D]. However,
the growth of isolates was decreased as compared to the control
with the increasing salt concentration. Salt tolerant isolates are a
good opportunity to fix nitrogen in highly saline and alkaline soil
to enhance the yield. Salt tolerant rhizobial inoculants mitigate the
effect of salinity and enhance yield in soybeans [25]. Similarly, high
salinity tolerance (up to 6%) of root nodule bacteria associated with
Medicago littoralis and Melilotus indicus was observed in the Algerian
Sahara [26]. Various phenotypic and biochemical characteristics of
each isolate are shown in [Table 2] . In the pH tolerance test, all isolates
Figure 2: Transverse Section of root nodule showing vascular bundles (VB)
and infection zone (IZ) in cortical region (A), Isolated pure colony (B), Sugar
utilization test (C), Salinity tolerance (D), pH tolerance (E), Acid and alkali
production (F) and Antibiotic resistance test (G)
Table 2:Phenotypic and biochemical activities shown by root nodule bacterial isolates of Melilotus indicus
showed visible growth on culture media having a pH of 5 to 10. Under
low pH (acidic) conditions, the growth of isolates was significantly
reduced, whereas at high pH (alkaline) conditions, growth remained
relatively stable compared to the control (Table 2) (Figure 2E). These
findings suggest a strong adaptive capability of the isolates to alkaline
conditions, reflecting their ecological suitability for the naturally
alkaline soils of the Aravalli region. All isolates tested for sugar
utilization and intrinsic antibiotic resistance test showed significant
variation in their carbon utilization (Table 3)(Figure 2C) and
intrinsic antibiotic resistance pattern (Table 4) (Figure 2G). In the
present study, we found that out of 21 sugars, fructose was the most
and adonitol was the least utilized sugar by the isolates. Different
utilization patterns of sugar can be used to identify the taxon [27].
Dierent sugar utilization patterns from the current investigation
showed resemblance with the study conducted on the Rhizobium
strain of Vicia faba root nodules in Ethiopia [28]. In Intrinsic antibiotic
resistance pattern, an investigation conducted on Rhizobium strains
of chickpea root nodules in Turkey, they observed that their majority
of isolates show resistance to chloramphenicol, kanamycin and
streptomycin [29]. In our investigation of antibiotic resistance,
most of the isolates showed resistance towards nitrofurantoin and
carbenicillin antibiotics. In the arid region of Morocco, endophytes
associated with chickpea (Cicer arietinum), faba bean (Vicia faba),
lentil (Lens culinaris) and common bean (Phaseolus vulgaris) were
tested for antibiotic resistance and found that isolates were resistant
to erythromycin, ciprooxacin, ampicillin and tetracycline [30]. In
our acid-alkali production test, 5 isolates showed alkaline production,
while 32 isolates showed acid production and the remaining 14 isolates
showed neutral reaction [Table 2] [Figure 2F]. A study conducted
on characterization of root nodules microsymbionts of Trigonella
foeniculum in Western Rajasthan found that most of their isolates are
acid producing, which is a characteristic of fast-growing bacteria [31].
The results of acid-alkali production from the present investigation
Figure 3:Biochemical and Plant growth promoting activities of RNB
isolates: Catalase activity (A), Gelatin hydrolysis (B), Nitrate reduction (C),
Citrate utilization (D), Indole production (E), Oxidase activity (F), Amylase
production (G), Cellulase activity (H), Phosphate solubilization (I), Protease
activity (J), Pectinase activity (K), Ammonia production (L) and Indole Acetic
Acid production (M)
Table 3:Utilization of sugars as carbon source by the root nodule bacterial isolates of Melilotus indicus
Table 4: Intrinsic Antibiotic Resistance shown by the root nodule bacterial isolates of Melilotus indicus
showed resemblances with the study conducted on root nodules
microsymbionts of Mung bean in Gypsiferous soil. They found that
9 out of 10 isolates are acid producing (fast growing) [32] A similar
study was conducted on microsymbionts of Zornia gibbosa in the
Aravalli range and found that out of 41 isolates 8 isolates showed acid
production while 8 isolates showed alkali production [33].
The variations in biochemical enzymatic activity of root nodule
bacterial isolates were reported by various authors[26-28, 33]. In the
present study, all isolates were characterized for their biochemical
properties and plant growth-promoting activities. The results are
presented in (Table 2) and (Table 5) respectively, and illustrated
in (Figure 2A-2M). In addtion, percentage of root nodule bacterial
strains showing sugar utilization, antibiotic resistance, various
biochemical and PGP activities are shown in (Table 6) for more
clarity and understanding. In our study, 34 isolates showed negative
results for gelatin hydrolysis. Similar results were observed in root
nodules bacterial strains isolated in Pisum sativum, who stated
that the majority of isolates showed a negative result of gelatin
hydrolysis [34]. Only one isolate (MI46) was found positive for indole
production. A study conducted on root nodule bacteria of Zornia
gibbosa in the central Aravalli range had similar results, in which
they found only one isolate (Z22) positive for indole production[33].
Indole production results were also observed in rhizobial strains of
lablab, cowpea and elephant plants [35].
Out of 51 isolates, 50 and 45 isolates showed a positive result
for catalase and oxidase activity, respectively. With high catalase
and oxidase activity, root nodule bacterial isolates enhance nitrogen
fixation. Similarly, all 8 rhizobial isolates associated with Cajanus
cajan in Telangana showed positive for catalase activity, while 7
isolates showed oxidase activity [36]. Rhizobium strains isolated
from Cicer arietinum and lentis also showed positive for catalase and
oxidase activity [37,38]. Citrate utilization activity showed whether
root nodule bacterial isolates utilize citrate as a carbon source or
not. In our findings, 10 isolates showed a positive result for citrate
utilization, while 14 isolates showed nitrate reduction. Root nodule
bacterial strains of Lablab purpureus and Vigna sinens is resulted in
Table 5:Plant growth promoting activities shown by root nodule bacterial isolates of Melilotus indicus
Table 6:Percentage of root nodule bacterial strains showing sugar utilization, antibiotic resistance, various biochemical and PGP activities
negative for citrate utilization [39], while another study found positive
for all isolates in root nodule bacterial strains (Mesorhizobium)
in chickpea [40]. Cellulase and amylase activity are significant in
the field of biotechnology and various industries. In our study, 10
isolates showed cellulase activity. Similar results were observed in the
central Aravalli region, 27 % isolates associated with root nodules of
Zornia gibbosa exhibited cellulase activity[33]. Similary in Ethiopian
region 48% root nodule bacterial strains asociated with groundnut
exhibited cellulase activity [41]. In addition, only two isolates (MI26
and MI34) from the present study showed starch hydrolysis. The
ability of the isolates to hydrolyze starch indicates their potential role
in decomposing complex carbohydrates, which may contribute to
improved nutrient availability and support plant growth.
Root nodule bacterial isolates were investigated for multiple plant
growth promoting activities (Table 5). Aer nitrogen, phosphorus
is the most critical element that limits plant growth. However, it is
found in high concentrations in some soils, but the plants utilizable
form of phosphorus is finite in soil because either, it forms insoluble
precipitates with metals (reaction with highly reactive Al3+ and Fe3+
in acidic, and Ca2+ in calcareous or normal soils) or is found in
organic form which is directly not assimilated by plants [42,43]. In
the present study 14 isolates showed a positive result for phosphate
solubilization. Phytohormones are low molecular weight chemical
messengers that coordinate cellular activities and stimulate plant
growth, and development such as Indole acetic acid [44]. Out of 51
isolates, 42 isolates showed positive results for indole acetic acid
production. Similarly, the positive result for IAA and phosphate
solubilization was observed by other researchers [33,45]. In addition,
the majority of isolates (43) gave positive results for ammonia
production, while 7 isolates showed protease activity. A similar study,
in the context of ammonia production, was reported from isolates of
root nodules of Sulla flexuosa [46]. During legume rhizobia symbiosis,
rhizobia faced penetration problems due to pectin. So the pectinase
activity may enhance penetration and nodule organogenesis. Out
of 51, only 5 isolates showed a positive result for pectinase activity.
Similar findings were reported for root nodule bacterial strain of
Glycine max. In their study, they found 5 isolates (out of 17) were
positive for pectinase activity [47]. In the present investigation, we
found the diversity between rhizobial isolates in terms of biochemical
and PGP activities. Applying beneficial microsymbionts that possess
plant growth-promoting features would help to remediate the crop
soil by reducing the need for chemical fertilizers and enhancing
adaptability for sustainable agriculture.
Conclusion
Melilotus indicus is a good fodder plant and is widely distributed
in the Aravalli region. In the present study, it was found that Melilotus
indicus had a well nodulated root system in all sampling sites in the
Central Aravalli region. All the 51 root nodule bacterial isolates from
the current investigation showed high tolerance towards salinity
and had significant variation in their sugar utilization and intrinsic
antibiotic resistance patterns. These isolates were highly diverse in
their physiological and biochemical characteristics and also had plant
growth-promoting activities. Therefore, these isolates can be utilised
as part of biofertilizers that can reduce the use of chemical nitrogen
fertilizers and favour sustainable agriculture.
References
12. Duke J (2012). Handbook of legumes of world economic importance. Springer Science Business Media.
Citation
Yadav A, Choudhary S, Sharma G, Sankhla IS. Phenotypical, Biochemical and Plant Growth Promoting Activities of Microsymbionts Associated with Melilotus indicus in Central Aravalli Region. J Plant Sci Res. 2025;12(2): 283